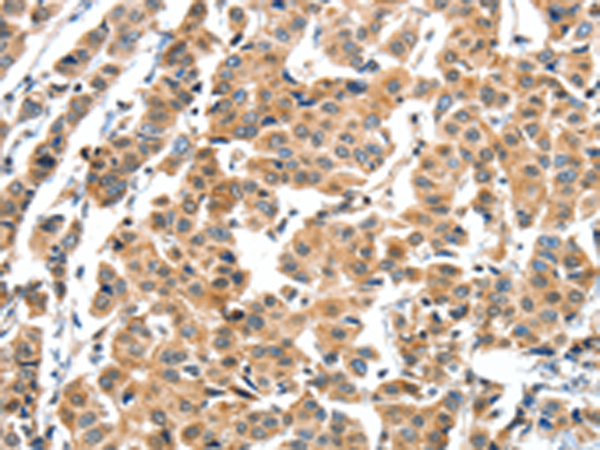

中文名稱:兔抗XBP1多克隆抗體
英文名稱: Anti-XBP1 rabbit polyclonal antibody
別 名: XBP2; TREB5; XBP-1
抗 原: XBP1
儲 存: 冷凍(-20℃)
宿 主: Rabbit
相關(guān)類別: 一抗
反應(yīng)種屬: Human
標 記 物: Unconjugate
克隆類型: rabbit polyclonal
技術(shù)規(guī)格
|
Background: |
This gene encodes a transcription factor that regulates MHC class II genes by binding to a promoter element referred to as an X box. This gene product is a bZIP protein, which was also identified as a cellular transcription factor that binds to an enhancer in the promoter of the T cell leukemia virus type 1 promoter. It may increase expression of viral proteins by acting as the DNA binding partner of a viral transactivator. It has been found that upon accumulation of unfolded proteins in the endoplasmic reticulum (ER), the mRNA of this gene is processed to an active form by an unconventional splicing mechanism that is mediated by the endonuclease inositol-requiring enzyme 1 (IRE1). The resulting loss of 26 nt from the spliced mRNA causes a frame-shift and an isoform XBP1(S), which is the functionally active transcription factor. |
|
Applications: |
ELISA, IHC |
|
Name of antibody: |
XBP1 |
|
Immunogen: |
Fusion protein of human XBP1 |
|
Full name: |
X-box binding protein 1 |
|
Synonyms: |
XBP2; TREB5; XBP-1 |
|
SwissProt: |
P17861 |
|
ELISA Recommended dilution: |
2000-5000 |
|
IHC positive control: |
Human breast cancer and human thyroid cancer |
|
IHC Recommend dilution: |
50-200 |
購物車
幫助
021-54845833/15800441009
